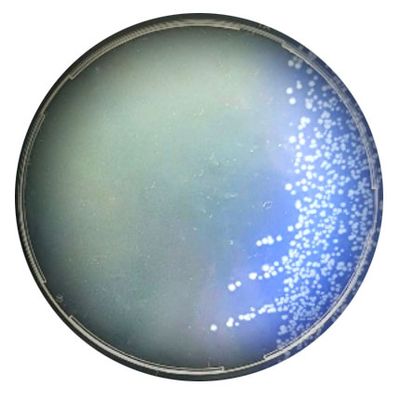
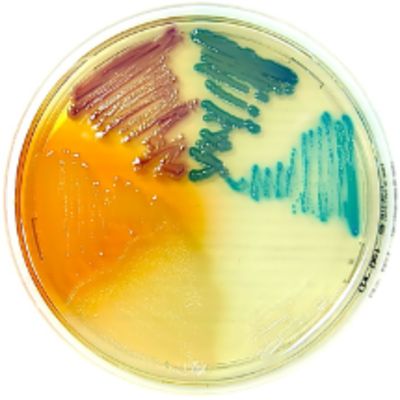

- Home
- Companies
- Liofilchem S.r.l.
- Products
Liofilchem S.r.l. products
Clinical Microbiology - Antimicrobial Resistance Management
Liofilchem - Model MTS - MIC Test Strip
Paper strips* for determining the Minimum Inhibitory Concentration (M.I.C.); The Liofilchem® MIC Test Strips is a quantitative assay for determining the Minimum Inhibitory Concentration (MIC) of antimicrobial agents against microorganisms to indicate appropriate patient treatment and for identifying resistance patterns. Liofilchem® MIC Test Strips are made of special high quality paper impregnated with a predefined concentration gradient of antibiotic, across 15 two-fold dilutions like those of a conventional MIC method. On one side of the strip a MIC scale in µg/mL is displayed and a code that identifies the antimicrobial agent. The Liofilchem® MTS™ (MIC Test Strip) range comprises over 150 agents. Each agent is available as 10/pack (individually packed), 30/pack (individually packed) or 100/canister pack.
Clinical Microbiology - Chromogenic Culture Media for Microbial Identification
Chromatic Clostridium Difficile
Fluorogenic medium for detecting C. difficile in clinical specimens and environmental samples. Clostridium difficile is the main responsible of nosocomial infectious diarrhea. The culture of C. difficile on agar plate is essential for further antimicrobial susceptibility testing or typization. With high sensitivity and specificity, Chromatic Clostridium difficile delivers microbial detection in 24 hours.
Chromatic Detection
Chromogenic medium for enumeration and identification of microorganisms from urinary specimens and food. Chromatic Detection allows an easy and reliable differentiation of a wide range of species, complete in case of urine samples. The addition of various antibiotics to the Chromatic Detection medium is also useful for the detection of critical nosocomial and multiple resistant microorganisms.
Clinical Microbiology
Liofilchem - Model VTM - Transport Medium for Viruses, Chlamydia, Mycoplasma and Ureaplasma
VTM is suitable for collection and preservation of clinical specimens containing viruses, including SARS-CoV-2 (COVID-19), Chlamydia spp., Mycoplasma spp. and Ureaplasma spp. The transport medium can be used with swabs and aspirates and is available in a plastic, screw cap tube. The transported microorganism remains viable for 48 hours at room or refrigerated temperature. VTM does not contain guanidium thiocyanate.
Liofilchem - Mycoplasma Transport Broth
Mycoplasma Transport Broth is a liquid medium used for the collection and transport of clinical specimens (e.g. vaginal and urethral swabs, seminal fluid, etc.) containing Trichomonas vaginalis, Gardnerella vaginalis, Candida spp, mycoplasmas and ureaplasmas from the collection site to the testing laboratory. The broth may be used as an enrichment medium as well.